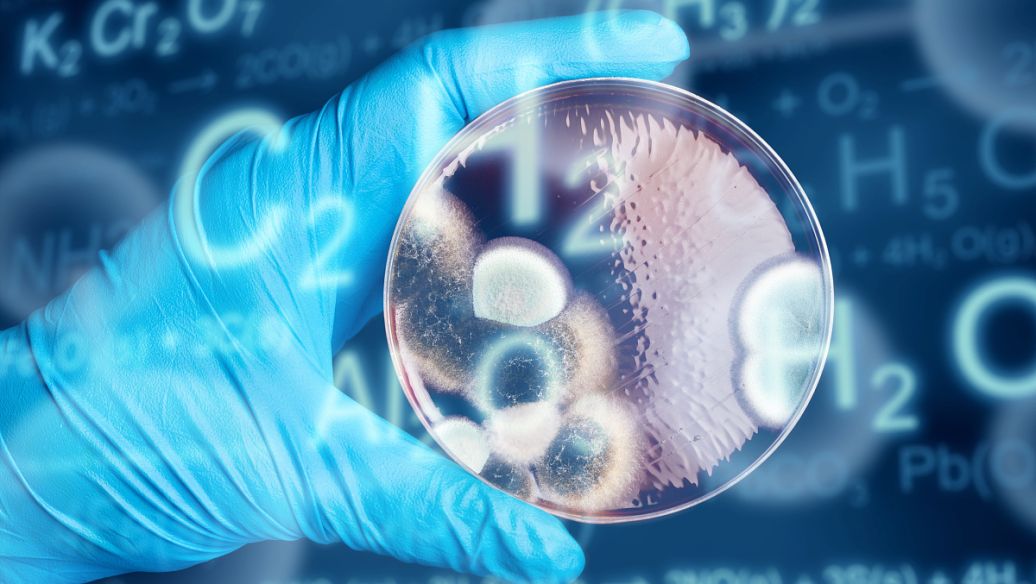

卵巢早衰在广州做第三代试管婴儿成功率高吗
2026-01-15 14:35
·
人浏览
我表妹因为卵巢早衰的原因,导致结婚好几年了都没有怀上,眼看年纪越来越大,就考虑做试管婴儿,目前想在广州做三代试管婴儿,请问下大家,卵巢早衰在广州做第三代试管婴儿成功率高吗?大概需要多少钱一次?...

最佳回答
卵巢早衰在广州做三代试管婴儿的成功率影响因素是受多方面因素影响的,例如患者年龄,医院技术水平,患者早衰的程度等等,具体的可以直接参考以下的表格:

| 早衰程度 | AMH 值 | 成功率范围 | 核心影响 |
|---|---|---|---|
| 轻度 | 0.5-1.4ng/ml | 20%-50% | 有一定基础卵泡,微刺激方案可能获卵 3-5 枚,染色体异常率约 60%,三代 PGT 筛选可提升成功率 |
| 中度 | 0.1-0.5ng/ml | 5%-15% | 卵子数量少、质量差,需多次促排积累胚胎,移植成功率低 |
| 重度 | <0.1ng/ml | <5% | 几乎无自主卵泡,常规促排效果差,建议考虑供卵,供卵后成功率可达 40%-50% |
注:上述表格内容仅提供参考,具体请以实际为准。
卵巢早衰患者做三代试管的成功率是没有一个固定的数据参考,这个需要根据患者早衰的实际情况,可以通过体检的方式让医生更好进行评估。据试管家小编了解到卵巢早衰在广州做三代试管婴儿的费用普遍是在10-15万元之间。
动费用构成:
1、前期检查:
包括夫妻双方染色体检查、传染病筛查、激素水平检测等基础项目,费用约5000至10000元。部分医院会根据病史增加专项检查。
2、促排卵药物:
进口药物单周期约2至3万元,国产药物费用可降低30%~50%。高龄或卵巢功能较差者可能需要多个周期促排。
3、取卵手术与胚胎培养:
含卵泡穿刺术、实验室胚胎培养(约1万元)及PGT基因检测(按胚胎数量收费,每枚胚胎筛查费3000至5000元)。
4、胚胎移植与保胎:
包含移植手术费及冷冻胚胎保存费(初次移植通常含1年存储)。移植后需使用黄体酮凝胶或针剂维持妊娠,持续用药至孕12周左右。
5、其他费用:
多余胚胎冷冻保存的年费(广州多数医院按管收费,每管1至2枚胚胎),如果第一次次移植失败,解冻复苏胚胎进行二次移植需额外支付手术及内膜准备费用。
卵巢早衰患者在广州做三代试管婴儿之前,一定要先进行体检,如果是轻度,可以通过要去进行调理,这样也能够增加成功率,如果是重度的,很有可能需要选择供卵,费用也会增加3-5万元之间不等,但是成功率也会高,这个要看患者的实际情况以及选择了。
更新时间 2026-01-15 14:35
交流群
位姐妹
高龄/绝经试管
助孕攻略群
加
群
群
位姐妹
不孕不育
助孕经验群
加
群
群
位姐妹
染色体异常
备孕交流群
加
群
群
位姐妹
三代/四代试管
助孕交流群
加
群
群
类似问题